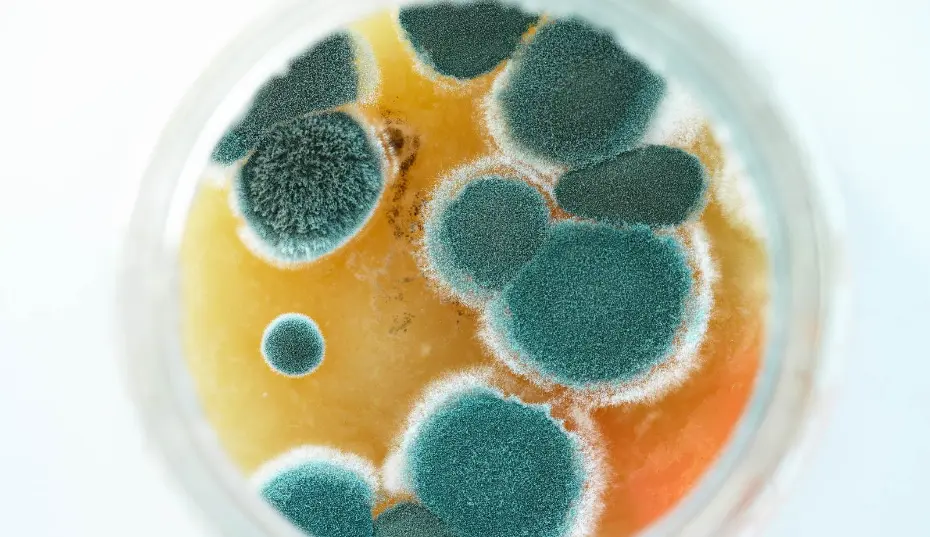

Mold thrives in Virginia Beach’s humid coastal climate, often hiding behind walls or under flooring where it quietly damages property and affects air quality. Many homeowners turn to DIY mold testing kits for quick answers, but these kits rarely tell the full story. DIY mold kits often miss hidden or airborne spores, giving a false sense of security instead of reliable results.
Professional inspections, like those offered by Mastertech, use precise methods and accredited laboratories to identify mold sources that DIY kits overlook. They consider local environmental factors—such as humidity, salt air, and seasonal weather shifts—that influence mold growth in ways a simple test kit cannot measure.
Understanding why DIY kits fall short helps homeowners make informed decisions about protecting their health and property. With accurate testing and expert insight, it becomes possible to address mold problems effectively before they worsen.
Why DIY Mold Testing Kits Fall Short in Virginia Beach
High humidity and frequent coastal storms in Virginia Beach create ideal conditions for indoor mold growth. Many residents turn to DIY mold testing kits to identify problems quickly, but these kits often provide incomplete or misleading results that fail to reflect actual indoor air quality or hidden contamination.
Common Misconceptions About DIY Mold Testing Kits
Homeowners often assume that a DIY mold testing kit can confirm whether their home is safe or contaminated. In reality, these kits only show that mold spores exist—which is true for nearly every indoor environment.
Mold spores are always present in the air, even in clean homes. A simple plate test cannot distinguish between normal background levels and a true contamination problem.
Another misconception is that these kits can identify the type of mold or its health impact. Most over-the-counter kits lack laboratory-grade analysis or chain-of-custody documentation. Without professional interpretation, results can easily be misunderstood, leading to unnecessary concern or false reassurance.
Limitations of Home Sampling Methods
DIY kits rely on passive sampling, such as leaving an agar plate exposed to the air or swabbing a visible surface. These methods do not measure airborne mold spores per cubic meter, which is the standard used in professional mold testing.
Environmental conditions—temperature, humidity, and airflow—can alter results. A sample collected in one room may not represent the rest of the property, especially when indoor mold hides behind walls or under flooring.
Professional inspectors use calibrated pumps, control samples, and accredited laboratories to ensure accuracy. DIY kits lack these controls, making it impossible to determine whether a detected mold level is elevated or within normal background range.
False Sense of Security from Incomplete Results
In Virginia Beach, moisture issues often occur in crawl spaces, basements, and HVAC systems where DIY kits cannot reach. When a test plate shows little or no growth, homeowners may assume their property is mold-free.
This false sense of security can delay proper remediation and allow hidden mold to spread. Kits also fail to detect non-viable spores, such as Stachybotrys or Chaetomium, which may remain harmful even when they no longer grow.
Without expert evaluation, incomplete results can lead to poor decisions about cleaning, repairs, or air quality management. Professional testing provides verified data and context that DIY methods simply cannot match.
The Hidden Dangers of Mold Missed by DIY Kits
DIY mold testing kits often fail to detect contamination hidden within walls, floors, and HVAC systems. These missed areas can continue to release mold spores into the air, worsening indoor air quality and allowing moisture problems to spread undetected.
Unseen Mold Growth Behind Walls and Floors
Mold frequently develops in concealed spaces where humidity and poor ventilation persist. Behind drywall, under flooring, or inside insulation, hidden mold can grow for months before visible signs appear.
DIY kits that rely on surface swabs or open-air samples rarely capture spores from these enclosed areas. Without professional inspection tools such as moisture meters or infrared cameras, homeowners may assume their property is safe when contamination continues to expand out of sight.
As mold feeds on cellulose materials like wood and drywall, it gradually weakens structural components. This slow deterioration can lead to costly repairs and persistent odor problems. Professional detection methods identify these hidden colonies early, allowing targeted remediation before damage becomes extensive.
Health Risks from Hidden Mold Spores
Even when not visible, mold spores circulate through indoor air and can affect occupants’ health. People with asthma, allergies, or compromised immune systems are especially sensitive to airborne spores.
DIY kits may confirm that mold exists but cannot measure spore concentration or compare indoor and outdoor levels. Without that context, results provide little insight into potential exposure risks.
Long-term exposure to elevated spore counts can cause coughing, nasal irritation, and fatigue. Prolonged contamination can also worsen chronic respiratory conditions. Certified inspectors use calibrated air sampling to determine whether indoor air quality meets safe standards and to locate the source of contamination.
Water Intrusion and Its Role in Mold Spread
Water intrusion from roof leaks, plumbing issues, or high humidity is one of the main drivers of mold growth. Moisture trapped behind walls or beneath flooring creates ideal conditions for spores to germinate.
DIY kits cannot identify these hidden moisture sources. A negative test result might mislead homeowners into ignoring leaks that continue feeding mold colonies.
Professionals use moisture detection tools to trace damp areas and verify whether structural drying is needed. Addressing the water source is essential; without that step, even cleaned surfaces can quickly become recontaminated.
Professional Mold Inspection vs. DIY Testing
Professional mold inspections rely on specialized instruments and trained assessment methods that detect contamination sources beyond what a homeowner can see or measure. Certified inspectors use diagnostic tools and structured procedures to locate hidden moisture and confirm the extent of mold growth before it spreads further.
Advanced Tools Used by Experts
Licensed inspectors use infrared cameras, moisture meters, and air sampling devices to identify mold that DIY kits often overlook. Infrared imaging reveals temperature variations in walls and ceilings that indicate trapped moisture or leaks. This helps pinpoint areas where mold may be forming behind drywall or under flooring.
Moisture meters measure the water content in building materials with precision. Professionals compare readings across multiple areas to find abnormal moisture levels that promote fungal growth. They may also use borescopes to look into wall cavities without cutting into the structure.
These tools provide measurable data that supports accurate diagnosis. The combination of thermal imaging, moisture detection, and air quality testing gives inspectors a detailed picture of contamination levels and environmental conditions inside the property.
Comprehensive Visual Inspection Techniques
A professional visual inspection complements instrument readings by identifying visible mold, discoloration, and water damage patterns. Inspectors evaluate walls, ceilings, flooring, HVAC systems, and plumbing fixtures for evidence of leaks or condensation.
They document findings through photographs and written notes, marking problem areas for further testing. This process often includes comparing indoor humidity readings and checking ventilation performance to locate recurring moisture problems.
Professionals follow a consistent inspection protocol that covers accessible and concealed spaces. They assess both the cause and the effect of mold presence, ensuring that remediation targets the source—not just surface growth. This thorough approach helps prevent recurring contamination in humid coastal environments like Virginia Beach.
The Importance of Accurate Mold Testing
Accurate mold testing ensures that both visible and hidden contamination are properly identified before remediation begins. Reliable data helps determine the extent of mold growth, the type of spores present, and whether indoor air quality poses a health concern. In coastal areas like Virginia Beach, where humidity levels remain high, precision in mold assessment is especially critical.
Why Mold Spores Are Hard to Detect
Mold spores are microscopic—typically 2 to 10 microns in size—and can remain suspended in the air for long periods. Because spores spread easily through HVAC systems and air currents, surface sampling alone rarely captures the full picture.
Professional inspectors often use a sampling pump to collect air samples at a controlled rate, measured in liters per minute. This method allows comparison between indoor and outdoor spore counts, helping identify abnormal elevations. DIY kits, by contrast, rely on passive collection methods that cannot measure airborne concentrations accurately.
Another challenge is that some spores are non-viable, meaning they do not grow in culture but can still trigger allergic reactions. Detecting these requires non-viable analysis using microscopy rather than petri dish growth. Without this level of testing, homeowners may underestimate contamination levels or miss hidden mold sources.
Challenges in Interpreting Test Results
Test results often include spore counts and species identification, but interpreting what those numbers mean requires expertise. A high total count in one room may not indicate contamination if outdoor levels are equally high.
Professionals use control samples and reference data to interpret results accurately. They also consider factors such as moisture readings, ventilation, and recent water damage. DIY kits typically omit these controls, leading to false positives or negatives.
Understanding laboratory reports also demands knowledge of threshold levels for common species like Aspergillus or Stachybotrys. Without proper context, homeowners may either overreact to harmless spores or ignore a serious problem that needs remediation.
Environmental Factors Affecting Mold Detection
In Virginia Beach, frequent humidity fluctuations and recurring moisture issues make mold detection challenging. Conditions such as high relative humidity, past water damage, and insufficient drying after leaks often create false negatives in DIY mold testing results.
Impact of Humidity and Moisture on Mold Growth
High humidity levels, often above 60%, allow mold spores to settle and grow on surfaces that appear dry. In coastal regions like Virginia Beach, moisture from the air can penetrate walls, insulation, and flooring materials. This hidden dampness makes it difficult for surface-level test kits to detect active mold colonies.
DIY kits typically rely on air or surface samples, but ambient humidity affects spore movement and concentration. A test performed on a dry day may show low spore counts even when hidden mold persists behind drywall or under flooring.
Professionals use moisture meters and hygrometers to measure water content in building materials. These instruments reveal damp areas invisible to the eye, helping locate the actual source of mold growth. Without this data, homeowners risk assuming the problem is resolved when conditions still support regrowth.
Role of Water Damage in Mold Outbreaks
Water damage from leaks, flooding, or condensation often triggers mold outbreaks that DIY kits fail to identify. Once materials like drywall or carpet absorb water, spores colonize within 24 to 48 hours, even if surfaces appear dry afterward.
In Virginia Beach, heavy rain and coastal storms increase the likelihood of hidden water intrusion. DIY test kits rarely account for these structural moisture pockets, leading to incomplete or misleading results.
Professional inspectors use moisture mapping and targeted sampling to trace water migration paths. This approach identifies concealed growth areas behind walls, under flooring, or inside HVAC systems—locations that simple swab or settle plate tests cannot reach.
Risks of Relying Solely on DIY Mold Testing Kits
DIY mold testing kits can give homeowners a false sense of security about indoor air quality. Inconsistent results, limited sampling methods, and lack of professional interpretation often lead to incomplete or misleading conclusions about mold presence and severity.
Potential for False Positives and Negatives
DIY mold testing kits often produce inaccurate readings due to uncontrolled sampling conditions. Temperature changes, humidity, and contamination during shipping or handling can distort results. A false positive may cause unnecessary concern, while a false negative can allow hidden mold growth to continue undetected.
Most kits only detect mold that grows on a culture plate. They fail to account for non-viable spores or spores that do not reproduce in the provided medium. This limitation can underestimate contamination levels, especially with species like Stachybotrys or Chaetomium that require professional non-viable analysis.
Without control samples or proper calibration, homeowners cannot compare indoor results to outdoor baselines. This lack of context makes it difficult to determine whether detected spores indicate a true problem or normal background levels common in Virginia Beach’s humid climate.
Overlooking Indoor Air Quality Issues
DIY mold test kits rarely measure airborne spores per cubic meter, a key indicator of overall indoor air quality. Mold spores often remain suspended in the air rather than settling on surfaces, meaning surface-only tests can miss major contamination sources.
Professionals use calibrated pumps and laboratory analysis to identify both viable and non-viable spores. These methods reveal how mold affects air circulation systems, wall cavities, and damp materials.
By focusing only on visible or surface mold, at-home kits overlook pollutants, humidity levels, and ventilation problems that contribute to poor air quality. This limited scope prevents homeowners from addressing the root causes of moisture and microbial growth effectively.
Mastertech’s Recommendations for Virginia Beach Homeowners
Virginia Beach’s humid coastal climate creates ideal conditions for indoor mold growth, especially in crawlspaces, basements, and bathrooms. Homeowners can reduce risks by knowing when to call certified professionals and by maintaining moisture control throughout the property.
When to Seek Professional Mold Inspection
Mastertech advises homeowners to schedule a professional mold inspection when they notice persistent musty odors, visible discoloration on walls or ceilings, or recurring moisture problems. These signs often indicate hidden mold that DIY kits cannot accurately detect.
Certified inspectors use moisture meters, thermal imaging, and air sampling to identify mold sources without unnecessary demolition. This process helps determine contamination levels and the most effective remediation plan.
Professional mold testing also provides lab-confirmed results, which are more reliable than consumer kits. DIY kits often produce false positives or fail to detect airborne spores, leading to incomplete cleanup.
In Virginia Beach, where humidity levels stay high much of the year, early professional evaluation prevents structural damage and protects indoor air quality. Homeowners should also seek inspection after flooding, plumbing leaks, or renovations that expose hidden building materials.
Preventive Steps for Maintaining a Mold-Free Home
Preventing indoor mold requires consistent moisture management. Homeowners should maintain indoor humidity below 50% using dehumidifiers and ensure that bathrooms, kitchens, and laundry areas have proper ventilation.
Regularly inspect and repair roof leaks, window seals, and HVAC condensation lines. In crawlspaces, Mastertech recommends encapsulation, which seals the area with vapor barriers to block ground moisture.
Simple maintenance habits make a difference:
- Clean and dry spills within 24–48 hours.
- Use exhaust fans during cooking and showering.
- Replace air filters every one to three months.
By controlling moisture and improving airflow, homeowners can significantly reduce the likelihood of mold returning after professional remediation.
Frequently Asked Questions
DIY mold testing kits often appear convenient but have significant limitations in accuracy, interpretation, and reliability. Professional testing provides more precise data through controlled sampling, accredited laboratories, and expert evaluation, which are especially important in humid coastal regions like Virginia Beach.
What are the limitations of at-home mold testing kits?
At-home kits typically lack expiration dates, control samples, and standardized collection methods. Many rely on passive air exposure or surface swabs that detect only visible or airborne spores in open areas. They also cannot identify hidden mold behind walls or in HVAC systems.
How does professional mold testing compare to DIY methods?
Professional testing follows established protocols and uses calibrated equipment to measure airborne spores per cubic meter. Certified inspectors collect samples under controlled conditions and send them to accredited laboratories for analysis. This process ensures accurate identification and quantification of mold types.
What factors can lead to inaccurate results with home mold test kits?
Improper handling, temperature fluctuations during shipping, and contaminated testing materials can distort results. Mold growth in petri dishes may reflect normal background spores rather than a problem area. Without environmental context, readings can be misleading or inconclusive.
Why might a professional be necessary for accurate mold detection?
Professionals can locate hidden moisture sources and identify both viable and non-viable spores. They interpret results within the context of building conditions and occupant health concerns. Their training allows them to recommend effective remediation strategies based on verified data.
What are common misconceptions about the effectiveness of DIY mold tests?
Many homeowners assume a positive culture automatically indicates a serious mold issue. In reality, mold spores exist naturally in all indoor environments. A test showing growth does not measure concentration or risk level without comparison to outdoor or control samples.
What guidelines does the CDC provide regarding mold testing?
The Centers for Disease Control and Prevention (CDC) does not recommend routine mold testing for homes. Instead, it advises identifying and correcting moisture problems promptly. Visible mold growth or a persistent musty odor is sufficient evidence to clean and repair affected areas without unnecessary testing.